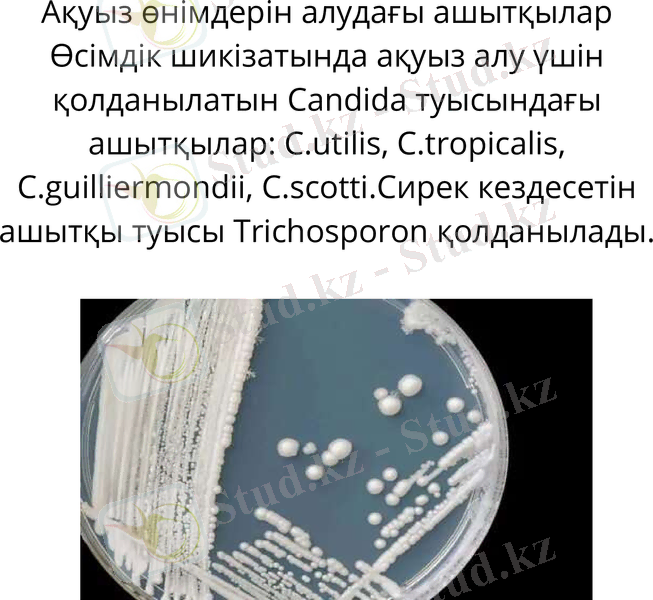
Slide 12
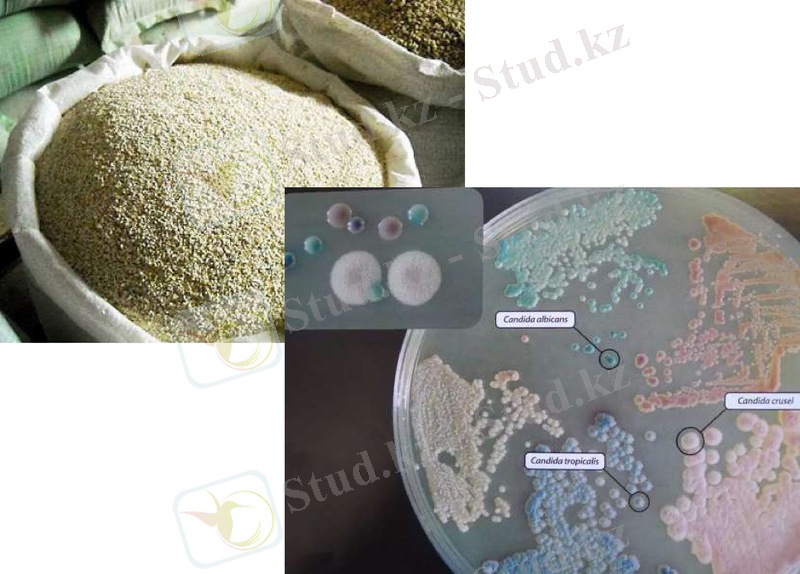
Slide 13
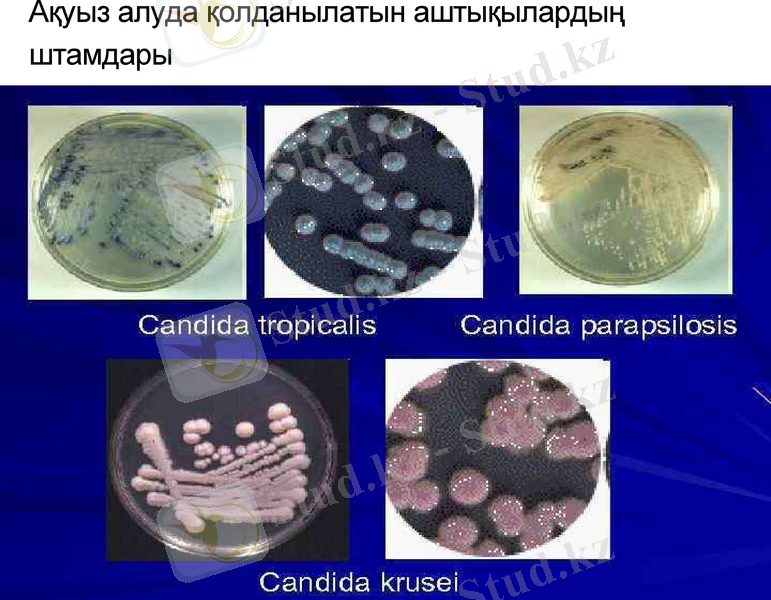
Slide 14

Ферментация жолымен алынған дәстүрлі ақуыз өнімдерінің микробиологиялық және тағамдық аспектілері



Ферментация жолымен алынған дәстүрлі ақуыз өнімдері
Орындаған: Сагидоллина Б
Қабылдаған: Тойжигитова Б
Қожа Ахмет Ясауи атындағы Халықаралық қазақ-түрік университеті
Түркістан 2023

Ақуыз- молекулалары өте күрделі
болатын аминқышқылдарынан
құралған органикалық зат; тірі
организмдерге тән азотты күрделі
органикалық қосылыс.
Аминқышқылдары қалдықтарынан
құралған жоғары молекуларлық
органикалық түзілістер. Ақуыз
организмдер тіршілігінде олардың
құрылысы дамуы мен зат алмасуына
қатысуы арқылы әртүрлі және өте
маңызды қызмет атқарады. Ақуызды
зат- құрамында міндетті түрде азоты
бар күрделі органикалық қосылыс.

Ақуыз тірі организмнің негізін құрайды, онсыз өмір
жоқ. Карл Маркстің пікір бойынша: «Тіршілік - ақуыз
заттарының өмір сүру формасы». Ақуыздар органикалық
заттар дамуының ең жоғарғы сатысы және жер бетіндегі
тіршіліктің негізі, организмнің тірек жүйесі, бұлшықет,
жамылғы ұлпалары ақуыздардан құралған. Олар
организмде әртүрлі маңызды қызмет атқарады: химиялық
реакцияларды жүргізеді, дене мүшелерінің қызметтерін
өзара үйлестіреді, аурулармен күреседі, т. б.
Ақуыздардың құрамы мен құрылысы өте күрделі.
Молекулалық массалары жүздеген мыңнан миллионға
дейін жетеді. Олардың құрылымы бұзылса, денатурацияға
ұшырап, организмдегі қызметін атқара алмайды.
Ақуыздар гидролизденіп, аминқышқылдарын түзеді және
өздеріне тән түсті реакциялары бар.

Ақуыздардың түрлері:
Қарапайым
Күрделі
протеиндер (альбуминдер,
глобулиндер, гистондар,
глутелиндер, проламиндер,
протаминдер, протеноидтар) ;
протеидтер
(гликопротеидтер,
нуклеопротеидтер,
липопротеидтер,
фосфопротеидтер)

Ақуыздардың мономерлері
аминқышқылдар болып табылады,
Ақуыздардың бірнеше түрі бар:
Треонин
Метионин
Лизин
Гистидин
Изолейцин
Фенилаланин
Лейцин
Валин


Ақуыздардың қызметі
Өршіткі қызметін атқаратын нәруыздар
Өршіткі қызметін атқаратын нәруыздар организмдегі химиялық реакцияларды жүзеге
асырады. Ферменттің катализдік белсенділігі өте жоғары болады. Олар реакцияның жүруін
ондаған, жүздеген мың есе тездетеді. Мысалы, қарын сөлінен бөлінетін пепсин ферменті
нәруыздарды протеидтерге дейін гидролиздейді.
Тасымалдау
Нәруыздардың келесі маңызды қызметі - тасымалдау. Нәруыздардың бұл тобы әртүрлі
маңызды заттарды жасуша ішінде және бүкіл организм бойынша бір жерден екінші жерге
тасымалдау қызметін жүзеге асырады. Мысалы, қан нәруызы гемоглобин оттекті қосып
алып, оны дененің бүкіл ұлпалары мен мүшелеріне таратады. Ал Альбумин жасушаның
энергетикалық шикізаты- май қышқылын тасымалдайды.

Қозғалыс қызметін атқаратын нәруыздар
Бұлшықеттің маңзды нәруыздары - актин және миозин. Нәруыздардың бұл тобы жасуша
мен организмдегі түрлі қозғалыс процестерін жүзеге асырады. Мысалы, хромосоманың,
талшықтардың қозғалуы.
Нәруыздардың жабынды тіректік және құрылыстық қызметі
Бұл топқа көптеген нәруыздар жатады. Мысалға, тасбақа сауыты, құс тұмсығы, тырнақ, шаш,
тері, ішек пен қантамырларлың қабырғасы осы нәруыздардан құралған. Құрылымдық
нәруыздар - микрофибрилдер де осы топқа жатады.

Белок өндіру мәселесінде микроорганизмдердің үлесі зор.
Микроорганизмдерден белок өндіргенде егістіктің, жайылымдардың
қажеті жоқ. Сонымен қатар ауа райына, сыртқы әсерлерге тәуелді емес.
Микрорганизмдердің белогы синтетикалық өнімдер қатарына
жатпайды. Солсебепті микрооорганизмдердің көмегімен белок өндіру
экономикалық тиімді процесс деп айтуға болады. Микроорганизмдер
клеткаларында, өсімдік және жануарлардағы сияқты, белоктан басқа
тағамдық құндылығы бар компоненттер, оның ішінденуклеин
қышқылдары, көмірсулар, аминқышқылдары, органикалық қышқылдар,
фосфолипидтер, витаминдер, микроэлементтер.

АҚУЫЗ ӨНІМДЕРІН ҮШ ТОПҚА БӨЛУГЕ БОЛАДЫ:
Бірінші топқа тағамға қатысты ақуыздарға ең бай өнімдер:
сүзбе, жержаңғақ, ірімшік және бұршақ тұқымдастар, соя
Екінші топқа дәл осындай ақуызға бай, бірақ тағамдық құнарлылығы жөнінен
төмен өнімдер: дәндіжануарлар мен жұмыртқа, балық дақылдардың өсімдіктер еті, дәндері
Үшінші топқа басқа құрамдары бойынша құнарлы, бірақ құрамында ақуыз
көлемі көп емес өнімдер:
Көкөністер, Жеміс-жидектер және сүт

Ақуыз өнімдерін алудағы ашытқылар
Өсімдік шикізатында ақуыз алу үшін
қолданылатын Candida туысындағы
ашытқылар: C. utilis, C. tropicalis,
C. guilliermondii, C. scotti. Сирек кездесетін
ашытқы туысы Trichosporon қолданылады.

Ақуыз алуда қолданылатын аштықылардың штамдары

Ақуыз өнімдерін алудағы бактериялар
Ақуыздың микроорганизмі - продуцентіне қоректік
көзі ретінде метан және газ сияқты гомологиясы
Preudomonas methanica, Ps. Fluorescens, Ps. Candatus,
Mycobacterium phley, Myc. filiformae, Myc. vadosum,
Myc. lacticolum, Myc. mycosum, Myc. luteum,
Myc. perrugosum жатады. Метил спиртінде ақуыз алу
үшін перспективті продуцент болып бактериялар,
ашытқылар, саңырауқұлақтар қолданылады.


Қорытынды
негізгі
мақсатының бірі ауылшаруашылығын тиімді азықтық ақуызбенқамтамасызету. Мал шаруашылықөнімі азықтық . Мал шаруашылығыжәнеқұс , негізінде . , картоп, азықтықшөптер сияқты бағалы өсімдік азығына микроэлеметті және витаминді, жарамдыақуыздытек қоспаретіндеқосқан кезде тиімді ғана тұтынуы мүмкін.

Қолданылған әдебиеттер:
1. Химия: Жалпы білім беретін мектептің жаратылыстану-
математика бағытындағы 11-сыныбына арналған оқулық / Ә.
Темірболатова, Н. Нұрахметов, Р. Жұмаділова, С. Әлімжанова. -
Алматы: «Мектеп» баспасы, 2007. - 352 бет. ISBN 9965-36-092-8
2. О. Д. Дайырбеков, Б. Е. Алтынбеков, Б. К. Торғауытов,
У. И. Кенесариев, Т. С. Хайдарова Аурудың алдын алу және
сақтандыру бойынша орысша-қазақша терминологиялық сөздік.
Шымкент. “Ғасыр-Ш”, 2005 жыл. ISBN 9965-752-06-0
3. Т. Мұсақұлов, ОРЫСША-ҚАЗАҚША ТҮСІНДІРМЕЛІ
БИОЛОГИЯЛЫҚ СӨЗДІК І-том ҚАЗАҚМЕМЛЕКЕТБАСПАСЫ,
Алматы - 1959, Редакциясын басқарған: Биология ғылымының
докторы профессор Т. Дарқанбаев
- Іс жүргізу
- Автоматтандыру, Техника
- Алғашқы әскери дайындық
- Астрономия
- Ауыл шаруашылығы
- Банк ісі
- Бизнесті бағалау
- Биология
- Бухгалтерлік іс
- Валеология
- Ветеринария
- География
- Геология, Геофизика, Геодезия
- Дін
- Ет, сүт, шарап өнімдері
- Жалпы тарих
- Жер кадастрі, Жылжымайтын мүлік
- Журналистика
- Информатика
- Кеден ісі
- Маркетинг
- Математика, Геометрия
- Медицина
- Мемлекеттік басқару
- Менеджмент
- Мұнай, Газ
- Мұрағат ісі
- Мәдениеттану
- ОБЖ (Основы безопасности жизнедеятельности)
- Педагогика
- Полиграфия
- Психология
- Салық
- Саясаттану
- Сақтандыру
- Сертификаттау, стандарттау
- Социология, Демография
- Спорт
- Статистика
- Тілтану, Филология
- Тарихи тұлғалар
- Тау-кен ісі
- Транспорт
- Туризм
- Физика
- Философия
- Халықаралық қатынастар
- Химия
- Экология, Қоршаған ортаны қорғау
- Экономика
- Экономикалық география
- Электротехника
- Қазақстан тарихы
- Қаржы
- Құрылыс
- Құқық, Криминалистика
- Әдебиет
- Өнер, музыка
- Өнеркәсіп, Өндіріс
Қазақ тілінде жазылған рефераттар, курстық жұмыстар, дипломдық жұмыстар бойынша біздің қор #1 болып табылады.



Ақпарат
Қосымша
Email: info@stud.kz